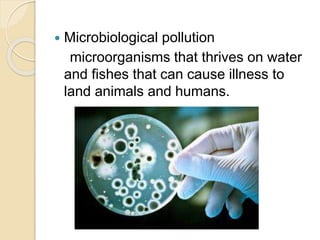
 Microbiological pollution
microorganisms that thrives on water
and fishes that can cause illness to
land animals and humans.

This document discusses water pollution, its sources, effects, and control measures. It defines water pollution as the contamination of water bodies that occurs when pollutants are directly or indirectly discharged without adequate treatment. Water pollution affects the entire biosphere and damages plant and animal species and communities. The major sources of water pollution include industrial waste, sewage, mining, oil spills, agricultural runoff, and urban development. Water pollution is measured through physical, chemical, and biological indicators and can cause diseases in humans and harm aquatic animals. Control measures involve regulating industries, wastewater treatment, public education, and research.